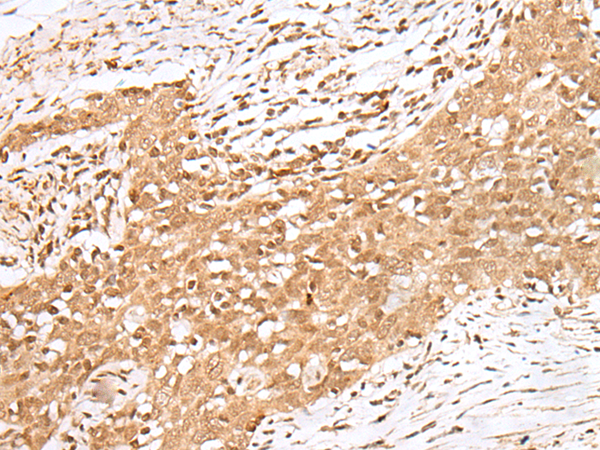

-
分类: 科研抗体货号: P05664别名: DR4; APO2; CD261; TRAILR1; TRAILR-1应用: WB,IHC反应种属: Human
-
分类: 科研抗体货号: P05614别名: HTX2; CFC1B; DTGA2; CRYPTIC应用: WB,IHC反应种属: Human
-
分类: 科研抗体货号: P05663别名: glypican应用: WB,IHC反应种属: Human, Mouse, Rat
-
分类: 科研抗体货号: P05612别名: CX31.1应用: WB反应种属: Human, Mouse, Rat
-
分类: 科研抗体货号: P05662别名: GLUT6; GLUT9; HSA011372应用: WB,IHC反应种属: Human
-
分类: 科研抗体货号: P05604别名: CEG1; EGFR-5; C14orf27应用: IHC反应种属: Human
-
分类: 科研抗体货号: P05661别名:应用: WB,IHC反应种属: Human
-
分类: 科研抗体货号: P05694别名: KRML; MCTO应用: WB,IHC反应种属: Human, Mouse, Rat
-
分类: 科研抗体货号: P05654别名: MKP4; MKP-4应用: IHC反应种属: Human
-
分类: 科研抗体货号: P05693别名: hMafA; RIPE3b1应用: WB,IHC反应种属: Human, Mouse

鄂公网安备42018502007531号
鄂公网安备42018502007531号

